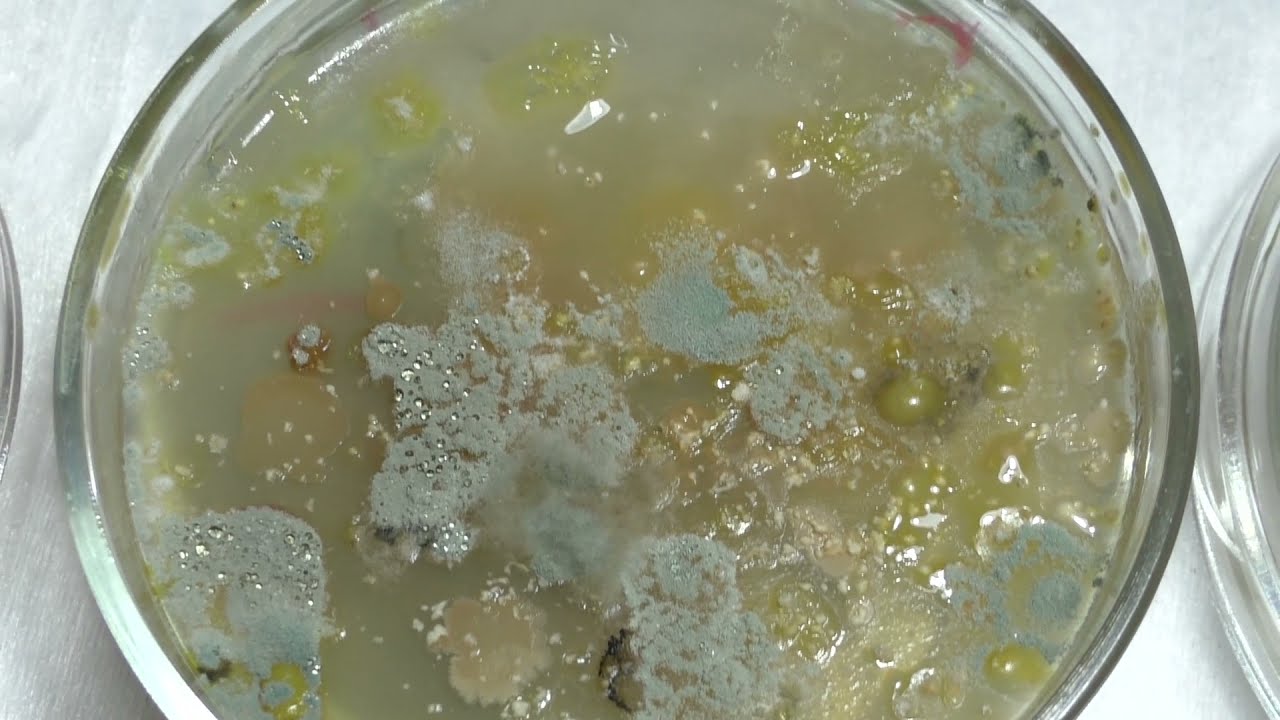

История петри
История петри 106 фото
Срочно нужен хозяин
Биматан глазные для роста ресниц отзывы
Японские покупки владивосток
Экономика полный курс
Владелец сети магазинов бристоль
Видеть во сне дохлых мышей
Самого нового блогера
Есть ли слон в московском зоопарке
Читательский дневник детей 1 класса
Ростовская область до скольки можно гулять
Xi xing ji kuang wang
Ми 17 ми 24
Всеобъемлющий разбор
Tier one game
Наилучшие божественные пожелания
Займ экспресс офисы
Куда можно поступить после 11 тюмень
Красивый детский заставка
Сколько страниц в книге всадник без головы
Ремкомплект суппорта фольксваген т5